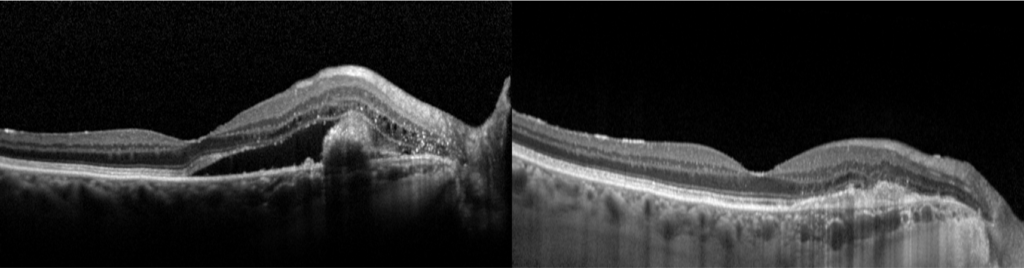

Vasculopathie Polypoïdale Choroïdienne (VPC)

Qu’est ce qu’une vasculopathie polypoïdale choroïdienne ? (VPC)
La VPC est une pathologie de la choroïde (tissu vasculaire sous la rétine) caractérisée par une dilatation anormale des vaisseaux choroïdiens et des dilatations anévrysmales terminales appelées « polypes ».
Cette atteinte s’accompagne de complications rétiniennes comme des hémorragies, des néovascularisations avec la présence de fluide intra ou sous rétinien, des ruptures de la membrane de Bruch …
Quels sont les symptômes d’une VPC ?
Certains patients restent longtemps asymptomatiques, quand l’atteinte n’affecte pas la macula. A l’inverse la vision peut chuter brutalement en cas d’hémorragie rétinienne. Le patient décrit alors une tache sombre, ou une perte de la vision périphérique, selon la localisation de l’hémorragie.
Les lignes peuvent paraitre déformées ou floues également.


Comment diagnostique-t-on une VPC ?
La mesure de l’acuité visuelle par l’orthoptiste permet d’évaluer la gène visuelle. Le diagnostic est ensuite confirmé par un bilan d’imagerie rétinienne multimodal.
L’OCT* (Tomographie par Cohérence Optique) permet de visualiser en coupe les différentes couches de la rétine, la présence de liquide intra ou sous rétinien. L’angiographie à la fluorescéine* et au vert d’indocyanine* permet de localiser les polypes, les différents points de fuite, et la présence de néovaisseaux anormaux.

Comment traiter les VPC ?
Trois monothérapies peuvent être utilisées pour traiter les polypes. Leur indication dépend de la localisation des polypes : proche du nerf optique ou de la macula, d’une première indication ou d’une lésion récidivante…
Ces traitements peuvent être complémentaires et réalisés de manière combinée pour une meilleure efficacité sur le long terme.
La photothérapie dynamique à la vertéporfine (PDT*). Il s’agit d’un laser non thermique réalisé en pleine ou demi fluence sur le polype, afin de l’occlure.
Les injections intra vitréennes d’Anti VEGF (IVT*). L’injection du médicament dans la cavité vitréenne permet de réduire l’exsudation et l’assecher le liquide intra ou sous rétinien mais ne permet pas d’occlure le polype.
La photocoagulation thermique direct du polype par laser Argon. Proposé pour les formes para papillaire ou très périphérique, et rarement en première intention.